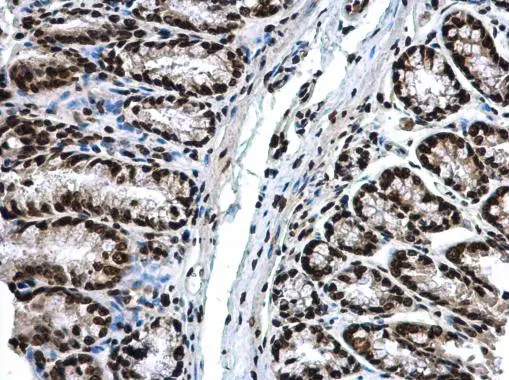

マイストア
変更
お店で受け取る
(送料無料)
配送する
納期目安:
2025.10.04 8:8頃のお届け予定です。
決済方法が、クレジット、代金引換の場合に限ります。その他の決済方法の場合はこちらをご確認ください。
※土・日・祝日の注文の場合や在庫状況によって、商品のお届けにお時間をいただく場合がございます。
immune ビスチェ ストレッチポリツイル ビスチェの詳細情報
ストレッチポリツイル ビスチェ。ストレッチポリツイル ビスチェ。セール】 レースキャミソールビスチェ《2025summer catalog item。immuneの渋谷PARCOで行われたPOP UPで購入したものです。購入してから4.5回しか着用していません。。Anti-Histone H3 antibody (GTX122148) | GeneTex。23区 洗えるリネンレーヨンストレッチ ジレ
ベストセラーランキングです
近くの売り場の商品
カスタマーレビュー
オススメ度 4.1点
現在、3281件のレビューが投稿されています。